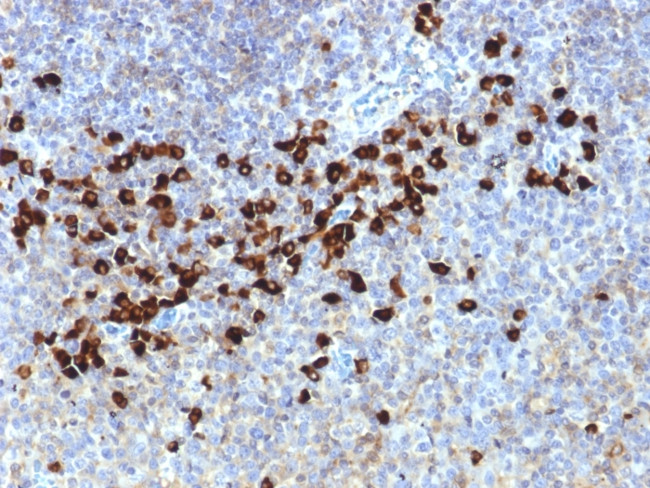
Lambda Light Chain (B-Cell Marker) Antibody in Immunohistochemistry (Paraffin) (IHC (P))

Search
NeoBiotechnologies
Lambda Light Chain (B-Cell Marker) Monoclonal Antibody (LLC/1738)
{{$productOrderCtrl.translations['antibody.pdp.commerceCard.promotion.promotions']}}
{{$productOrderCtrl.translations['antibody.pdp.commerceCard.promotion.viewpromo']}}
{{$productOrderCtrl.translations['antibody.pdp.commerceCard.promotion.promocode']}}: {{promo.promoCode}} {{promo.promoTitle}} {{promo.promoDescription}}. {{$productOrderCtrl.translations['antibody.pdp.commerceCard.promotion.learnmore']}}
产品信息
3535-MSM8-P0
种属反应
宿主/亚型
分类
类型
克隆号
抗原
偶联物
形式
浓度
纯化类型
保存液
内含物
保存条件
运输条件
靶标信息
Immunoglobulin classes share the same basic four polypeptide chain structure of two heavy chains (five types) and two light chains (kappa, lambda; both having a molecular weight of 22.5 kDa). Kappa and lambda consist of a variable region and a constant region and can easily be differentiated by the antigenic properties of the constant region. The ratio of kappa to lambda is 70:30. Antibodies to the kappa light chain are reportedly useful in the identification of leukemias, plasmacytomas, and certain non-Hodgkin's lymphomas. Demonstration of clonality in lymphoid infiltrates indicates that the infiltrate is clonal and therefore malignant.
仅用于科研。不用于诊断过程。未经明确授权不得转售。
篇参考文献 (0)
生物信息学
蛋白别名: Bence Jones Protein; BJP; IGL; IGLC 1/2/3; Immunoglobulin L; immunoglobulin lambda light chain; Lambda LC; Mcg Marker; Paraprotein
基因别名: IGLC; IGLV
Entrez Gene ID: (Human) 3537, (Human) 3546